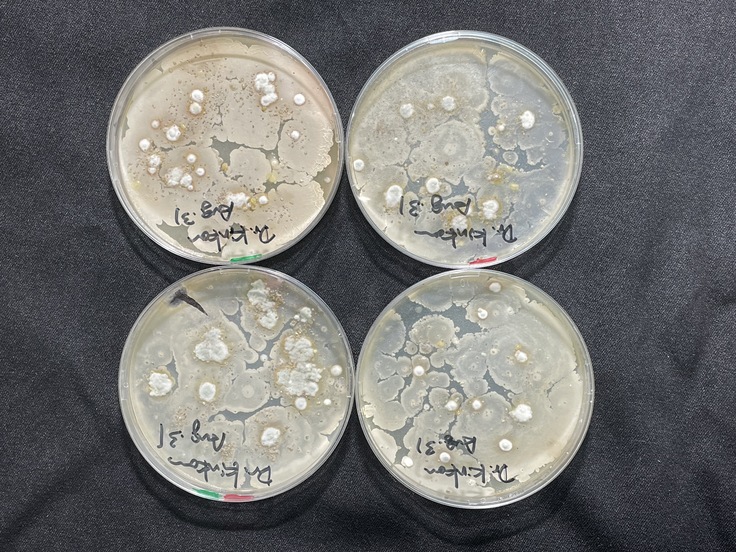

寄付総額
目標金額 600,000円
- 寄付者
- 83人
- 募集終了日
- 2021年2月1日
ビール作りだけでなく卒論修論の研究やってます!👨🎓
ツクツクボウシの声も少なくなり、秋の気配が深まってきています。
9月後半に大学の後期が始まります。学生の皆さんはそれまで夏休みを満喫🍉!?
いえいえ、次の麦シーズンを目の前に、8月に積み残した実験データを測定することと論文の執筆に向かい研究室のセミナーで💦議論を交わしています。そして夏前に収穫した大麦で、いよいよ次のクラフトビール作りの段取りを練り始めています。
今日はそんな研究室活動の紹介です。🧪🧫
地球規模での気候変動で、世界の重要な食料であるコムギの生産も大きな影響を受けています。そんな厳しい環境変化に順応して作物を収穫するためには、土の中に元気な根をしっかり張って土台をしっかりと育てることが一つの切り口になります。(学生時代に鍛えられてしっかり根を張り、立派な穂をつける🌾...学生さんの学びと成長と重なりますね😃)
植物は1人で環境と闘っているのではありません。土の中や葉の表面、そして体の中にも目に見えないたくさんの微生物が共生して、助け合いながら生きています。ヒトの腸内細菌を健全に保つことが健康につながると言われます。最近では、「植物の根はひっくり返った腸」と言われるように根の周り(根圏問いいます)にたくさんの微生物が共生して、良い環境を作ることで健全に育つことが注目されています。どうやって良い根圏環境をコムギ自身が作り上げるか、それに関わる遺伝子を探して、気候変動に頑健性や回復力を発揮して持続して収穫できる品種改良を目指す研究をしています。
では、実験室の中を覗いてみましょう。
土壌微生物を培養して、善玉菌を見つけ出す実験です。
学生さんが探しているのは菌根菌というキノコ(カビ)の仲間の微生物です。いろいろな色と形の菌が出てきます。
菌根菌は、根っこに感染して植物にリン酸や水の栄養成分を運んでくれます。植物は菌根菌に糖分やアミノ酸を供給して良い共生関係を作り出します。それにより、根が届く範囲(根系)よりはるかに広い範囲に菌糸のネットワークが広がり、しっかりした土台が出来上がります。お庭や家庭菜園で草を抜いたとき、根っこに土が沢山ついてきますよね。あれは菌根菌の菌糸が蜘蛛の巣のように土地の粒を巻き込んで「菌根」になった状態です。

さてさて、どんな菌が増えてきたでしょう🔬
根毛ほどの太さの菌糸が、キラキラ光って広がっています。丸く見えるのは胞子が入った袋(いわゆるキノコの部分です)。栗と白がありますが、キチン成分を染める色素で染色してUVライトで観察してみると、生きている部分が白く光、枯れているところが黒くなっています。すざまじい勢いで成長し、あっという間に根系を広げてくれます。

なんとか、うまく培養できたようですね。
これで実験はおわりではなく、これからが本番です。多様な種類のコムギにこの菌根菌を接種して、きょうせいしやすい小麦とそうでないコムギの遺伝子源を選び出し、そこから善玉菌を呼び込みやすいコムギの遺伝子を探すこと、その共生関係を強化する生物刺激剤(バイオスティミュラント)の効果を探ることです。
田んぼの雑草であるアオウキクサから植物性に脂肪酸が抽出されており、その液に種まき前にイネやコムギの種子をつけてから育てると、環境変化に強くなり育つ免疫作用が生まれます。その結果、少ない肥料で農薬を使わなくてもたくましく育つ、まさにSDGsを目指した研究です。
夏場は暑くて麦が育てられないので、この夏に水稲のコシヒカリでその生物刺激剤を効果を検証してみました。(以前お話ししたハウスの田んぼは、50°Cを地球温暖化を想定したスケールアップした実験です)

左の写真のように出穂期まで穂あまり生育に差がないようです(先生には、生物刺激剤を処理した方が出穂期が1日遅く、若干背が低くみて取れました)。学生さんは初めての稲作、時に水やりを忘れたりしてかなり厳しい環境変動に見舞われたそうです。
登熟が始まった右側の写真では、ほら違いが分かりますね!処理をしていない右側のポットが黄色く色づき始めていますが、処理したポットはまだ葉が生きてしっかり光合成をしてお米の粒を大きくしています。これは、しっかり根が張っていたので、厳しい(学生さんが与えた)環境変動でもめげずに底力を発揮して育っているという様子です。
これからの、卒論と修論の最終段階が楽しみですね!
来月には、新しい3年生が研究室にやってきます。
引き続き、みなさんのご指導をよろしくお願いいたします👨🎓👨🌾
======================
🍺 さて、いよいよ今シーズンのビールつくりを始動します。
コルンムッターを醸造いただくサンクトガーレンの岩本さんが、NHKテレビに登場します。📺
SanktGallenBrewery / 元祖地ビール屋 サンクトガーレン
2019年8月に放映された、美の壺「日々を潤す ビール」が下記日程で再放送されます。
ビールの泡、色、香りの3つの要素に注目。サンクトガーレンは“色”のパートで登場します。
9月12日(日) NHK Eテレ1 23:00~23:30
9月16日(木) NHK Eテレ1 11:00~11:30
https://www.nhk.jp/p/ts/Y5X4W21ZN2/schedule/ts/NL6KV9YLVX/
映像が美しく、見ているとビールが飲みたくなります。お時間のある方はぜひ。
======================
ギフト
3,000円

KORNMUTTER カード
● 寄附金領収書
●麦畑の周りの身近な自然を写したカードです。いろいろな生き物たちの暮らしぶりを解説して紹介します。
※3,000円×複数口でのご寄附も可能です。(「寄附する」ボタンを押していただいた先の画面右上で、個数を選択できます。)
- 申込数
- 45
- 在庫数
- 制限なし
- 発送完了予定月
- 2021年5月
10,000円

KORNMUTTER カードと「全集中、麦の呼吸」オンラインイベントへのご招待
● 寄附金領収書
●KORNMUTTERカードは、麦畑の周りの身近な自然を写したカードです。いろいろな生き物たちの暮らしぶりを解説して紹介します。
●サンクトガーレンとのコラボでのオンラインイベントや、コロナを吹っ飛ばす「全集中、麦の呼吸」のオンラインセミナーへご招待いたします。
※オンラインイベントやセミナーは、2021年5月〜9月の期間で開催予定です。Peatixにてご招待をお送りする予定です。
※1万円×複数口でのご寄附も可能です。(「寄附する」ボタンを押していただいた先の画面右上で、個数を選択できます。)
- 申込数
- 42
- 在庫数
- 制限なし
- 発送完了予定月
- 2021年5月
3,000円

KORNMUTTER カード
● 寄附金領収書
●麦畑の周りの身近な自然を写したカードです。いろいろな生き物たちの暮らしぶりを解説して紹介します。
※3,000円×複数口でのご寄附も可能です。(「寄附する」ボタンを押していただいた先の画面右上で、個数を選択できます。)
- 申込数
- 45
- 在庫数
- 制限なし
- 発送完了予定月
- 2021年5月
10,000円

KORNMUTTER カードと「全集中、麦の呼吸」オンラインイベントへのご招待
● 寄附金領収書
●KORNMUTTERカードは、麦畑の周りの身近な自然を写したカードです。いろいろな生き物たちの暮らしぶりを解説して紹介します。
●サンクトガーレンとのコラボでのオンラインイベントや、コロナを吹っ飛ばす「全集中、麦の呼吸」のオンラインセミナーへご招待いたします。
※オンラインイベントやセミナーは、2021年5月〜9月の期間で開催予定です。Peatixにてご招待をお送りする予定です。
※1万円×複数口でのご寄附も可能です。(「寄附する」ボタンを押していただいた先の画面右上で、個数を選択できます。)
- 申込数
- 42
- 在庫数
- 制限なし
- 発送完了予定月
- 2021年5月

貧困・虐待などで親を頼れない若者に伴走支援を|若者おうえん基金
- 現在
- 7,125,000円
- 支援者
- 332人
- 残り
- 6日

三浦半島から新しい教育文化を創る!
- 現在
- 5,110,000円
- 支援者
- 124人
- 残り
- 41日

10周年記念事業「東北ゼブラ会議 2026」開催!東北創生の次代へ
- 現在
- 940,000円
- 支援者
- 33人
- 残り
- 31日

食を通して人が繋がる居場所「えんくる」を応援してください
- 総計
- 11人

国立科学博物館マンスリーサポーター|地球の宝を守りつづける
- 総計
- 679人

吉村作治エジプト調査隊 太陽の船 大エジプト博物館展示へ【第一弾】
- 現在
- 5,870,000円
- 支援者
- 153人
- 残り
- 67日

豪雨災害で崩壊した参道修復を。重要文化財・舟城神社を未来へ繋ぐ。
- 現在
- 4,165,000円
- 支援者
- 65人
- 残り
- 8日

米どころ山形・庄内平野のど真ん中にゲストハウスを作りたい!
- 支援総額
- 1,545,000円
- 支援者
- 156人
- 終了日
- 8/31
築43年の実家(空き家)を、こどもたちの学び場に改装したい!
- 支援総額
- 2,915,000円
- 支援者
- 277人
- 終了日
- 9/30

なんだべ村、10年目の節目。今こそ、みんなで村を綺麗にしっぺ!
- 支援総額
- 1,345,000円
- 支援者
- 100人
- 終了日
- 1/31

コロナ禍により絶たれた家族の時間|タブレット面会システム導入へ
- 支援総額
- 3,121,000円
- 支援者
- 109人
- 終了日
- 12/24
東京スタジアム(味スタ)周辺な西調布のカフェを増設したい!
- 支援総額
- 2,183,000円
- 支援者
- 43人
- 終了日
- 9/6

愛知県東三河で486匹の見捨てられない命を守るために。
- 支援総額
- 3,178,000円
- 支援者
- 317人
- 終了日
- 2/27

大切なペットが安心できる状態で診察を。往診事業を始めたい!
- 支援総額
- 939,000円
- 支援者
- 65人
- 終了日
- 7/30